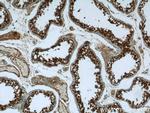
DHX57 Antibody in Immunohistochemistry (Paraffin) (IHC (P))

Search
Proteintech
DHX57 Polyclonal Antibody
{{$productOrderCtrl.translations['antibody.pdp.commerceCard.promotion.promotions']}}
{{$productOrderCtrl.translations['antibody.pdp.commerceCard.promotion.viewpromo']}}
{{$productOrderCtrl.translations['antibody.pdp.commerceCard.promotion.promocode']}}: {{promo.promoCode}} {{promo.promoTitle}} {{promo.promoDescription}}. {{$productOrderCtrl.translations['antibody.pdp.commerceCard.promotion.learnmore']}}
产品信息
24525-1-AP
种属反应
宿主/亚型
分类
类型
抗原
偶联物
形式
浓度
规格
纯化类型
保存液
内含物
保存条件
运输条件
产品详细信息
This antibody reacts with 150 kDa DHX57 protein.
Immunogen sequence: PLEYAGLAS VEPYVPEFTV SPFAVQKLSR YGFNTERCQA VLRMCDGDVG ASLEHLLTQC FSETFGERMK ISEAVNQISL DECMEQRQEE AFALKSICGE KFIERIQNRV WTIGLELEYL TSRFRKSKPK ESTKNVQENS LEICKFYLKG NCKFGSKCRF KHEVPPNQIV GRIERSVDDS HLNAIEDASF LYELEIRFSK DHKYPYQAPL VAFYSTNENL PLACRLHISE FLYDKALTFA ETSEPVVYSL ITLLEEESEI VKLLTNTHHK YSDPPVNFLP VPSRTRINNP ACHKTVIPNN SFVSNQIPEV EKASESEESD EDDGPAPVIV ENESYVNLK (163-500 aa encoded by BC131534)
靶标信息
Probable ATP-binding RNA helicase.
仅用于科研。不用于诊断过程。未经明确授权不得转售。
篇参考文献 (0)
生物信息学
蛋白别名: DEAH (Asp-Glu-Ala-Asp/His) box polypeptide 57; DEAH box protein 57; DEAH-box helicase 57; DEAH-box RNA/DNA helicase AAM73547; Putative ATP-dependent RNA helicase DHX57; unnamed protein product
基因别名: DDX57; DHX57
UniProt ID: (Human) Q6P158
Entrez Gene ID: (Human) 90957